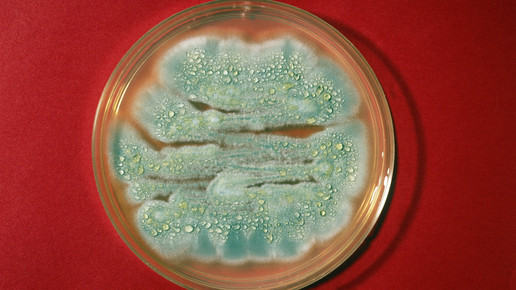

Interaktionen und Nebenwirkungen: Antibiotika Teil 1
Bei bakteriell bedingten Infektionen verschaffen Antibiotika schnelle Linderung. Je nach Erkrankung können unterschiedliche Wirkstoffarten eingesetzt werden. Jeder Arzneistoff hat seine ganz eigenen Neben- und Wechselwirkungen, einen Auszug davon behandelt dieser erste Teil.
Wirkungsweise und Dosierung
Antibiotika können auf zwei verschiedenen Wegen wirken: Bakteriostatisch wirksame Arzneistoffe hemmen das Wachstum und die Vermehrung von Bakterien, ohne diese abzutöten. Bakterizide Antibiotika hemmen das Wachstum und töten darüber hinaus die Erreger ab. Innerhalb dieser Gruppe unterscheidet man zwischen zwei weiteren Untergruppen: Primäre oder auch absolute Bakterizide richten sich gegen ruhende und proliferierende Bakterien. Sekundäre Bakterizide richten sich hingegen nur gegen proliferierende Bakterien. Die Anzahl an Bakterien, auf die ein einzelnes Antibiotikum wirkt, ist unterschiedlich groß. Bei einem großen Wirkspektrum spricht man von Breitbandantibiotika.
Der genauere Wirkmechanismus unterscheidet sich nach dem Wirkort. Bestimmte Arzneistoffe können die Zellwandsynthese hemmen, andere hemmen die bakterielle Proteinbiosynthese am Ribosom. Neuere Arzneistoffe zeigen eine Wirkung auf die bakteriellen Nukeleinsäuren und können die DNA-Replikation hemmen oder durch Strangbrüche zu DNA-Schäden führen.
Die vergleichsweise gute Verträglichkeit von Antibiotika erklärt sich unter anderem durch folgende Fakten: Bakterien sind die einzigen bekannten Organismen, deren Zellwand aus Murein besteht. Dieser Zucker kommt ausschließlich in Bakterien vor. Weiterhin ist es so, dass Bakterien andere Ribosomen zur Proteinbiosynthese besitzen als der Mensch. Die Enzyme, die zur DNA-Replikation genutzt werden, unterscheiden sich ebenfalls. Humanzellen bilden im Gegensatz zu Bakterien keine Folsäure – Menschen nehmen das Vitamin mit der Nahrung auf.
Einteilung nach Wirkmechanismus
Hemmung der Zellwandsynthese
- Beta-Lactam-Antibiotika
- Penicilline
- Cephalosporine
- Monobactame
- Carbapeneme
- Glykopeptid-Antibiotika
Hemmung der bakteriellen Proteinbiosynthese
- Aminoglykoside
- Makrolide
- Lincosamide
- Tetrazykline
- Chloramphenicol
- Ketolide
- Lipopeptide
- Oxazolidinone
Störung der DNA/RNA
- Chinolone
- Rifampicin
- Nitromidazol-Derivate
Störung der Folsäure-Bildung
- Sulfonamide
- Trimethoprim
Getrennt betrachtet werden die Antibiotika zur Behandlung von Tuberkulose. Sie zählen zur Gruppe der Antituberkulotika und richten sich gezielt gegen den Auslöser der Erkrankung.
Die Dosierung ist individuell und richtet sich nach der Erkrankung selbst, sowie der Dauer und der Ausprägung der Symptome. Es gibt zwar einige Präparate am Markt, die einem festen Dosierungsschema folgen, die patientenindividuelle Dosierung sowie die Dauer der Einnahme wird jedoch vom behandelnden Arzt festgelegt.
Nebenwirkungen und Überdosierung
Beta-Lactam-Antibiotika
Innerhalb dieser Gruppe werden Penicillin V (Phenoxymethylpenicillin) und Amoxicillin häufig zur oralen Anwendung verordnetet.
Penicillin V: Unter der Einnahme kommt es häufig zu gastrointestinalen Störungen (Übelkeit, Erbrechen, Durchfall). Viele Menschen reagieren allergisch auf Penicilline, diese Unverträglichkeit kann sich im schlimmsten Fall durch einen anaphylaktischen Schock äußern. Sofortreaktionen weisen auf eine echte Penicillin-Allergie hin und erfordern einen Therapieabbruch. Darüber hinaus kann es zu Hautausschlägen und Schleimhautentzündungen kommen. Eine seltene, aber erklärungsbedürftige, Nebenwirkung ist die sogenannte Schwarzhaarzunge. Diese Nebenwirkung ist ungefährlich und klingt nach Absetzen der Therapie wieder ab. Da die therapeutische Breite von Penicillinen hoch ist, ist bei Überdosierungen nicht mit Vergiftungserscheinungen zu rechnen.
Amoxicillin: Auch bei diesem Wirkstoff kommt es häufig zu, Erbrechen und Durchfall. Hautauschläge kommen etwas seltener als unter der Einnahme von Penicillin V vor. Bei einer Überdosierung kann es zur sogenannten Amoxicillin-Kristallurie kommen die unbehandelt zur Niereninsuffizienz führen kann.
Cephalosporine
Innerhalb dieser Gruppe wird Cefuroxim häufig verschrieben. Weitere Vertreter dieser Klasse finden eher im Klinikbereich Anwendung. Die Einnahme von Cephalosporinen kann zu einem vermehrten Wachstum von nicht empfindlichen Mikroorganismen führen, häufig steigt die Anzahl von Candida-Stämmen. Darüber hinaus kann es zu einer antibiotika-assoziierten Kolitis kommen. Unter der Einnahme von Cefuroxim kann es zu Erkrankungen des Blutes kommen: Die Ausbildung einer Eosinophilie kommt häufig vor. Thrombozytopenie und Leukopenie treten gelegentlich auf. Es kann zu einem vorrübergehenden Anstieg der Leberenzyme kommen. Verschiedene gastrointestinale Beschwerden wie Bauchschmerzen und Durchfall treten häufig auf. Bei einer Überdosierung kann es zu neurologischen Störungen wie Krampfanfällen kommen. Die Dosierung für niereninsuffiziente Patienten muss dementsprechend angepasst werden.
Tetrazykline
Doxycyclin gehört zu den oral angewendeten Arzneistoffen innerhalb der Gruppe der Tetrazykline. Unter der Einnahme kommt es häufig zu Sodbrennen, Magendruck, Fettstühlen und Blähungen. Wer ein Tetrazyklin einnimmt sollte auf intensive Sonnenbestrahlung verzichten. Unter UV-Licht können phototoxische Reaktionen entstehen, diese äußern sich zumeist in starkem Sonnenbrand, Rötung, Schwellung und Blasenbildung. Die belichteten Hautareale können sich ungewöhnlich stark verfärben. Tetrazykline können nephrotoxische Schäden hervorrufen. Patienten mit bestehender Niereninsuffizienz sollten aufgrund möglicher Verschlimmerung der Grunderkrankung auf andere Antibiotika ausweichen. Bei Überdosierungen kann es zu Leberschäden oder zu einer Pankreatitis kommen.
Makrolide
Die Wirkstoffe Azithromycin, Roxythromycin und Clarithromycin gehören zu der Gruppe der Makrolide. Zu den häufigsten Nebenwirkungen gehören Übelkeit, Erbrechen und Kopfschmerzen. Es kann zu Sehstörungen und Schwindel kommen. Häufig sind bestimmte Leukozytenwerte unter der Einnahme erhöht. Gelegentlich kann eine Hepatitis entstehen. Anfängliche Hörstörungen können sich als Tinnitus manifestieren. Die Haut sollte während der Einnahme keinem direkten Sonnenlicht ausgesetzt werden, da es zur Lichtempfindlichkeit kommen kann. Makrolide können unerwünschte Arzneimittelwirkungen auf den Knochen- und Bewegungsaparat haben – es kann zu Myalgien, Osteoarthritis, Rücken- und Nackenschmerzen kommen.
Gyrasehemmer
Eine Untergruppe der Gyrasehemmer sind die Chinolone und Fluorchinolone. Zu den häufig verordneten Wirkstoffen innerhalb dieser Arzneistoffgruppe gehören Ofloxacin, Levofloxacin und Ciprofloxacin. Ofloxacin wird im außerklinischen Bereich meist nur ophthal bei Sekundärinfektionen angewendet. In Krankenhäusern wird der Arzneistoff in der Regel nur noch bei schweren Infektionen eingesetzt. Ähnlich sieht es mit Levofloxacin aus, außerhalb der Klinik spielt der Wirkstoff keine große Rolle. Anders sieht es bei Ciprofloxacin aus: Verordnungen werden häufig bei Atemwegsinfektionen wie Sinusitis und eitriger Otitis media ausgestellt. Auch Blasenentzündungen werden mit Ciprofloxacin behandelt. Die am häufigsten berichteten Nebenwirkungen sind Übelkeit und Durchfall. Gelegentlich kann sich unter der Einnahme eine mykotische Superinfektion entwickeln. Es kann zu Kopfschmerzen, Benommenheit, Schlafstörungen und Geschmacksstörungen kommen. Weiterhin treten häufig psychomotorische Hyperaktivitäten und Agitiertheit (krankhafte Unruhe) auf. Während der Einnahme sollte kein Sport getrieben werden: Übermäßige Bewegung ist aufgrund möglicher Sehnenrisse und Muskel- sowie Gelenkreizungen zu vermeiden. Eine Überdosierung von mehr als 12 g führt zu Toxizitätssymptomen wie Beeinträchtigung der Nieren- und Leberfunktion. Die Einnahme solch hoher Mengen ist unwahrscheinlich.
Weitere Antibiotika – Fosfomycin
Dieser Arzneistoff gehört zur Gruppe der Epoxid-Antibiotika und wird seit den 70er Jahren als hochdosierte Einmalgabe gegen Blasenentzündung angewendet. Durch die einmalige Einnahme fallen gastrointestinale Nebenwirkungen gering aus. Es kann zu Durchfällen kommen, diese halten jedoch meist nur für kurze Zeit an. Häufig kommt es zu vorübergehenden Kopfschmerzen und Schwindel. Zu einer ebenfalls häufigen unerwünschten Arzneimittelwirkung gehört die Vulvovaginitis, hierbei handelt es sich um eine chronische Entzündung der Vulva und der Scheide. Symptome sind neben Jucken und Brennen ein verstärkter Ausfluss. Akute Toxizität konnte nur bei extremer Überdosierung von 5 g pro kg KG beobachtet werden.